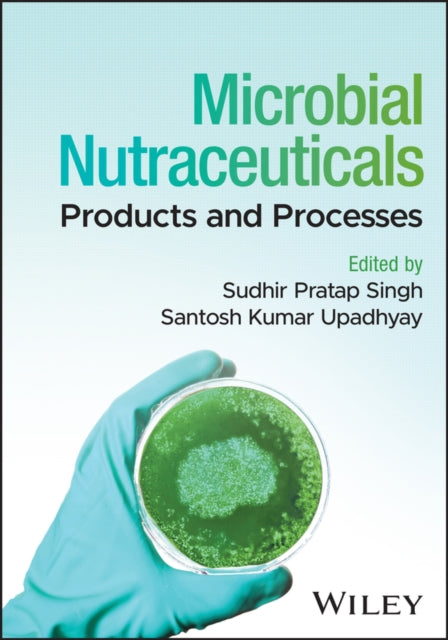

1
/
of
1
Shulph Ink
Microbial Nutraceuticals: Products and Processes
Microbial Nutraceuticals: Products and Processes
Low Stock: Only 1 copies remaining
Regular price
£133.88 GBP
Regular price
£150.00 GBP
Sale price
£133.88 GBP
Unit price
/
per
Taxes included.
Shipping calculated at checkout.
YOU SAVE £16.12
- Condition: Brand new
- UK Delivery times: Usually arrives within 2 - 3 working days
- UK Shipping: Fee starts at £2.39. Subject to product weight & dimension
Bulk ordering. Want 15 or more copies? Get a personalised quote and bigger discounts. Learn more about bulk orders.
Couldn't load pickup availability
- More about Microbial Nutraceuticals: Products and Processes
Format: Hardback
Length: 496 pages
Publication date: 21 August 2025
Publisher: John Wiley & Sons Inc
Weight: 1158g
Dimension: 183 x 262 x 32 (mm)
ISBN-13: 9781394241507
This item can be found in:
UK and International shipping information
UK and International shipping information
UK Delivery and returns information:
- Delivery within 2 - 3 days when ordering in the UK.
- Shipping fee for UK customers from £2.39. Fully tracked shipping service available.
- Returns policy: Return within 30 days of receipt for full refund.
International deliveries:
Shulph Ink now ships to Australia, Belgium, Canada, France, Germany, Ireland, Italy, India, Luxembourg Saudi Arabia, Singapore, Spain, Netherlands, New Zealand, United Arab Emirates, United States of America.
- Delivery times: within 5 - 10 days for international orders.
- Shipping fee: charges vary for overseas orders. Only tracked services are available for most international orders. Some countries have untracked shipping options.
- Customs charges: If ordering to addresses outside the United Kingdom, you may or may not incur additional customs and duties fees during local delivery.